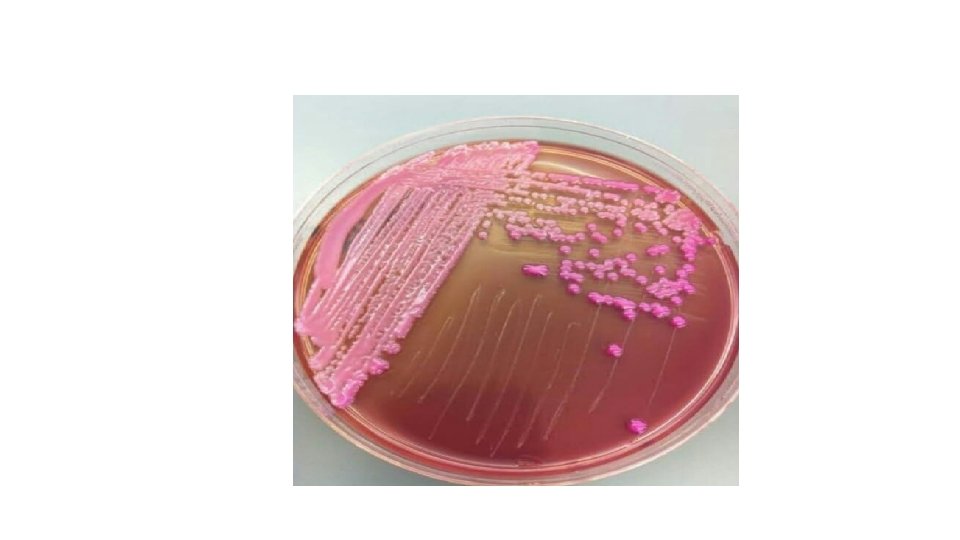
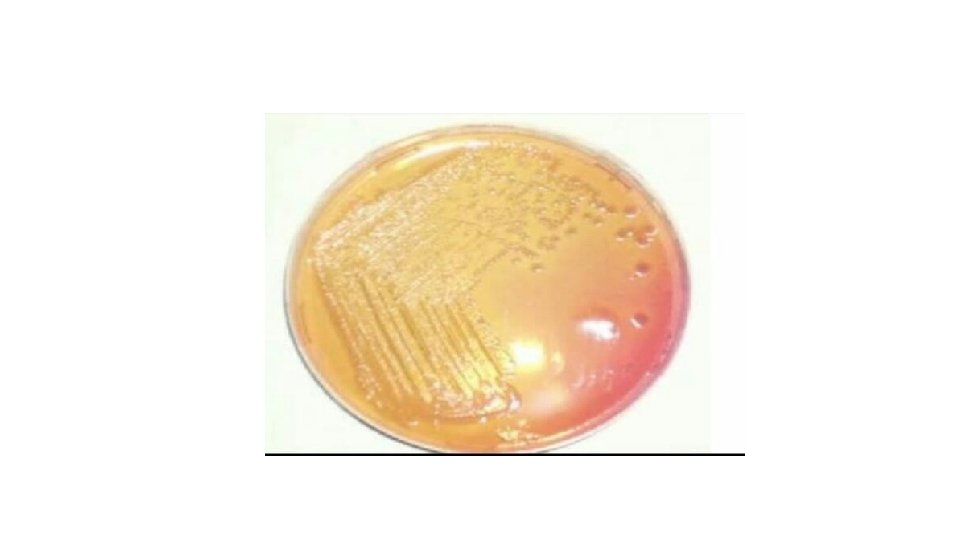
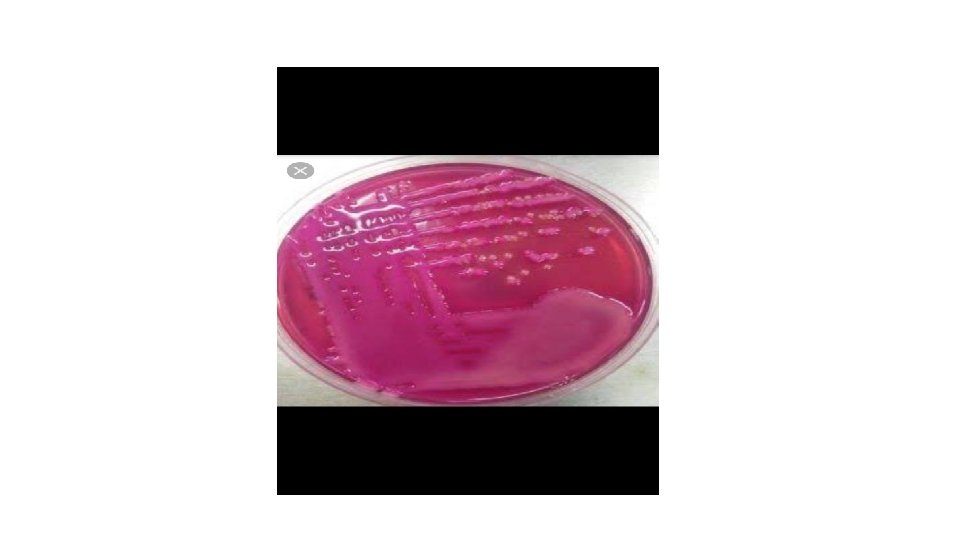

Mac Conkey Agar Plate Name Desai Himani Patel

- Slides: 20
Mac. Conkey Agar Plate Name = Desai Himani Patel Juli Panchal amita Field = MLT College= Shree Manavata Seva Trust , MLT
Mac. Conkey Agar Plate
v. Definition of agar Agar is a gelatinous substance , thick and clear substance that comes from seaweed and used in biological culture media and as a thickener in foods.
v Definition of mac. Conkey agar Mac. Conkey agar is an indicator , a selective and differential culture medium for bacteria designed to selectively isolate Gram-negative and enteric ( normally found in the intestinal tract ) bacilli and differentiate them based on lactose fermentation.
The crystal violet and bile salts inhibit the growth of gram positive organisms which allows for the selection and isolation of gram negative bacteria. Enteric bacteria that have the ability to ferment lactose can be detected using the carbohydrate lactose , and the p. H indicator neutral red.
v History The medium was developed by Alfred Theodore Mac. Conkey while working as a bacteriologist for the Royal Commission on Sewage Disposal.
v Principle Mac. Conkey agar is used for the isolation of gram-negative enteric bacteria and the differentiation of lactose fermenting from lactose non-fermenting gram-negative bacteria. Pancreatic digest of gelatin and peptones(meat and casein) provide the essential nutrient, vitamin and nitrogenous factors required for growth of microorganism. Lactose monohydrate is the fermentable source of carbohydrate.
• The selective action of this medium is attributed to crystal violet and bile salt, which are inhibitory to most species of gram-positive bacteria. Sodium chloride maintains the osmatic balance in the medium. Neutral red is a p. H indicator that turns red at a p. H below 6. 8 and is colorless at any p. H greater than 6. 8. Agar is the solidifying agent.
v Contents It contain bile salt (to inhibit most Grampositive bacteria), Crystal violet dye (which also inhibits certain Gram-positive bacteria), Neutral red dye (which turns pink if the microbes are fermenting lactose).
v Composition • • • Peptone - 17 g Proteose peptone -3 g Lactose - 10 g Bile salt - 1. 5 g Sodium chloride - 5 g Neutral red - 0. 03 g crystal violet - 0. 001 g Agar – 13. 5 g Distilled water – add to make a 1 litre
Preparation of Mac. Conkey Agar 1. Suspend 49. 53 grams of dehydrated medium in 1000 ml purified/distilled water. 2. Heat to boiling to dissolve the medium completely. 3. Sterilize by autoclaving at 15 lbs pressure (121 c)for 15 minutes. 4. Cool to 45 -50 C. 5. Mix well before pouring into sterile petri plates.
v Uses Using neutral red p. H indicator, the agar distinguishes those gram –negative bacteria that can ferment the sugar lactose ( Lac+) from those that cannot (Lac-) This medium is also known as an “indicator medium” and a “low selective medium”. Presence of bile salt inhibits swarming by proteus species.
v Lac positive By utilizing the lactose available in the medium , Lac+ bacteria such as Escherichia coli , Enterobacter , klebsiella will produce acid , which lowers the p. H of the agar below 6. 8 and results in the appearance of pink colonies. The bile salts precipitate in the immediate neighbourhood of the colony, causing the medium surrounding the colony to become hazy.
v Lac negative Examples of non – lactose fermenting bacteria are salmonella , Proteus species , Pseudomonas aeruginosa and Shigella.
v Mucoid colonies Some organisms , especially Klebsiella and Enterobacter , produce mucoid colonies which appear very moist and sticky. This phenomenon happens because the organism is producing a capsule , which is predominantly made from the lactose sugar in the agar.
ORGANISM COLOUR REMARKS Escherichia coli Aerobacter aergenes Enterococcus species Staphyloccus species Pseudomonas aeruginosa red/pink non-mucoid red minute, round pale pink opaque green- brown fluorescent growth
Thank You